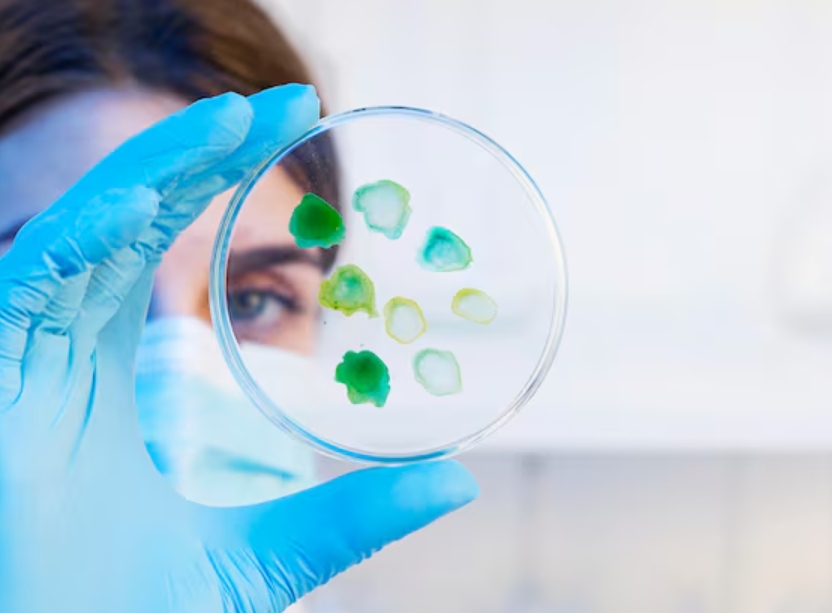
the Crucial Role of Primary Antibodies in Immunochemistry
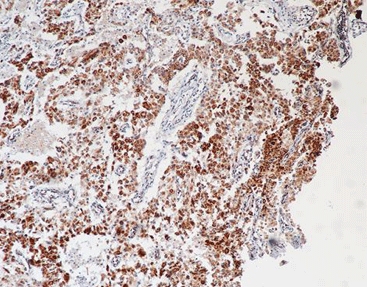
primary antibody SDHB(21A11AE7), MMab

2026-02-06
By admin
In the complicated field of modern cancer care, the gap between a major diagnosis and a lost chance often depends on the tiny link between one protein and a special molecule. That molecule is the primary antibody. In Immunohistochemistry (IHC), the primary antibody acts as the main “finder,” made to locate and attach to certain antigens in tissue samples.
Without its accuracy, even the best staining tools and scanners would lack direction. At Celnovte, we specialize in providing high-quality primary antibodies, ensuring reliable diagnostic results that guide pathologists in making precise cancer diagnoses.
At its heart, a primary antibody is an immunoglobulin built to spot and connect with a particular epitope on a target protein. This connection marks the initial and most important step in the IHC process. When a pathologist aims to figure out a tumor’s source or a biomarker’s level, they count on the antibody’s skill to skip countless unrelated proteins and stick only to the right one. This “lock-and-key” match lets doctors sort cancers that appear the same under a basic H&E stain.
Simplified Comparison: Monoclonal vs. Polyclonal Antibodies
| Category | Monoclonal (Celnovte Focus) | Polyclonal |
| Specificity | Binds to a single epitope | Binds to multiple epitopes |
| Consistency | High repeatability; stable engineering | High batch-to-batch variation |
| Background | Clean signal; minimal non-specific binding | Higher risk of background noise |
| Production | Large-scale, high-yield platforms | Limited by animal host |
| Validation | 41 “Optimal” NordiQC ratings | Variable performance |
While both kinds play a part, monoclonal antibodies (MAbs), like those from Celnovte, give better reliability. Our murine and human monoclonal antibodies come from high-expression vectors and stable engineering platforms. This makes sure every batch offers the same strong sensitivity and specificity, which is key for standard clinical work where changes between batches might cause uneven outcomes.
The primary antibody is essential for telling apart tumors that look alike but differ in genes. For example, in rare eosinophilic renal tumors, studies have confirmed the solid performance of Celnovte’s SDHB antibody in giving a clear diagnosis. By correctly spotting the presence or absence of certain proteins, pathologists can point surgeons toward the best treatment route, which cuts down on delayed or wrong diagnoses.
In the time of precision medicine, primary antibodies go beyond simple tests; they serve as companion diagnostics. They help decide if a patient qualifies for targeted treatments, such as Antibody-Drug Conjugates (ADCs). Checking ADC targets like HER2, TROP2, and c-Met through IHC and multiplex IHC (mIHC) is vital for boosting antitumor effects while reducing overall harm.
Human Epidermal Growth Factor Receptor 2 (HER2) is a key biomarker in breast and gastric cancer diagnostics. Celnovte’s HER2 (Clone: C1F7) is a murine monoclonal antibody that has earned a Class III NMPA registration certificate. This antibody is designed for the qualitative determination of HER2 antigen in paraffin-embedded tissue sections.
The strength of the C1F7 clone comes from its clear membrane staining. In recent NordiQC assessments, our self-cloned HER2 antibody has regularly gained “optimal” ratings, showing its skill in separating various levels of protein overexpression (0, 1+, 2+, 3+) with good repeatability. This accuracy matters a lot, as it shapes whether a patient gets HER2-targeted therapy.

For hormone receptor testing, Celnovte offers highly validated clones, including the Progesterone Receptor (Clone: C4D10). Our ER and PR antibodies have been awarded optimal NordiQC assessments for six consecutive years. In 2022, our ER antibody obtained a Class III registration certificate from the NMPA, the highest level of regulatory approval in China.
The main benefit of these antibodies is their firm nuclear staining and minimal background. By using our stable engineering expression platform, we keep batch-to-batch differences small, giving pathologists full trust in each slide.
Our SDHB (Succinate Dehydrogenase Complex Iron Sulfur Subunit B) antibody is another sample from our specialized lineup. Research using Celnovte SDHB antibodies has pointed out their role in examining the shape differences in rare kidney tumors. The high sensitivity of this clone permits the detection of SDHB deficiency, which signals certain hereditary paraganglioma and renal cell carcinoma syndromes.
Founded in 2010, Celnovte has set itself up as a high-tech leader focused on tumor precision diagnosis. Headquartered in Rockville, Maryland, for reagent development, with massive manufacturing facilities in Zhengzhou, China, we have built a complete industrial chain integrating R&D, production, and service. Our facilities are NMPA and GMP compliant, and we hold certifications for ISO13485, ISO9001, FDA, and CE IVDR.
With over 1,000 automated IHC stainer installations globally and a portfolio of over 400 ready-to-use primary antibodies, Celnovte focuses on providing integrated solutions that raise diagnostic accuracy. We believe that quality is the life of the enterprise, and this idea guides our strict antibody development process.
The job of a primary antibody tells only part of the tale; the rest involves how that attachment shows up. Celnovte has created the MicroStacker™ Detection System, which uses a small polymer frame to layer F(ab’) fragments of secondary antibodies and peroxidase enzymes.
When matched with a good primary antibody, MicroStacker™ provides:
Better Sensitivity: The small build allows deeper tissue reach and a stronger signal boost.
No Background: Skipping streptavidin and biotin removes non-specific staining from natural biotin.
Quick Results: When combined with our PolyStacker™ technology, intraoperative rapid frozen IHC can finish in as little as 10 to 15 minutes with full confidence.
![[Instrument] MicroStacker™ Flex Polymer Detection Kit](http://www.celnovte.com/wp-content/uploads/2026/02/Instrument-MicroStacker™-Flex-Polymer-Detection-Kit.jpg)
Authority and rigor form the base of Celnovte’s R&D. Out of our 120+ self-cloned primary antibodies, 41 have won “optimal” or “good” NordiQC assessments. NordiQC is an independent, international organization that checks the quality of IHC staining across labs worldwide. Earning an “optimal” rating means our antibodies, such as TTF1 and CD10, deliver the top standard of staining results available today in the industry. This outside check proves that our reagents meet the tough needs of leading hospitals and research sites in over 40 countries.
The primary antibody remains the most important tool for pathologists. As we shift toward tougher diagnostic methods like Multicolor Immunohistochemistry, which permits spotting multiple antigen targets on one slide at once, the need for high-specificity primary antibodies will keep rising.
At Celnovte, we stand by this change. By pairing our award-winning primary antibodies with fully automated platforms like the CNT 360 and CNT 320, we are simplifying workflows and making certain every patient gets a diagnosis rooted in the most exact molecular proof. Our mission is straightforward: to boost precision in cancer diagnostics and improve patients’ lives through new ideas.
A: Yes, we offer over 400 ready-to-use primary antibodies, though concentrated versions are also available for specific laboratory needs.
A: Absolutely. Using our PolyStacker™ technology and specialized primary antibodies, staining can be completed in as little as 10-15 minutes.
A: Our products are compliant with ISO13485 and ISO9001 standards, and many key antibodies hold NMPA Class III, FDA, or CE IVDR certifications.
A: While optimized for Celnovte’s CNT series, our antibodies are designed for high compatibility and can be validated for use on most open automated systems.